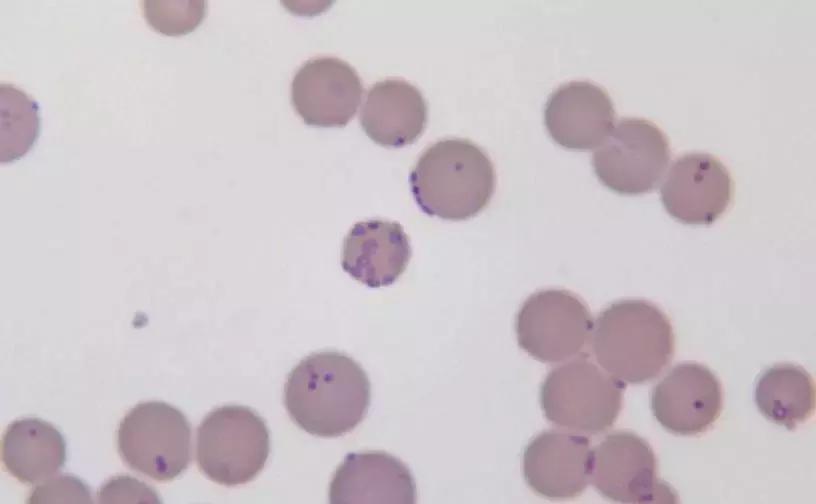
穿好奶奶织的毛裤，你依旧无法避免与风湿膏药共度晚年

每逢冬天,几乎所有中国父母都会要求孩子们穿上一条秋裤。
他们总说年轻不能太任性,总觉得身体扛得住寒冷,到老了就容易患上风湿。
关节疼痛多难受?光是想想就能体会得到,于是穿不穿秋裤成了每个年轻人共同的选择题。
但是,老一辈的经验就真的是正确的吗?

不过,其实这样的观点是混淆了逻辑关系的。
因为风湿这类疾病,造成关节钙化损伤,从而对气温气压变化比较敏感。
患了病后,受寒便会出现收缩痉挛,引起疼痛不适。
单衣单裤御寒,一年四季冷水洗澡,终于有一天发现疼痛难忍,换做是谁都容易认为受风受寒才是患上风湿的最大原因。

膝关节有严重的继发性骨关节炎
而且老一辈常说的风湿,与现代医学所定义的风湿也根本不是同一个东西的。
传统医学对风湿的认识,早在《皇帝内经》中就有记载:“ 风寒湿三气杂,合而为痹 ”。
在传统的认知中,风寒湿邪确实会阻塞经络、关节,气血不畅从而导致发关节疼痛。
不过其实根据不同的“气杂”程度,还定义了不同的其他症状,例如畏寒、发热、肝虚肾亏等等。
可见古人所说的风湿病,其实是指“气杂”导致的一系列疾病。

《黄帝内经》目录、内页
古籍中不仅记载了致病因素,还描写了诱发疾病的场景。
《左传》、《战国策》中还记载了许多“病例”,将天阴雨湿、久卧湿地、酒色过甚归纳为诱发风湿的因素。
由此可见,传统医学认为受寒只是疼痛的诱因,风湿病更多认为是“伤了气”,需要滋养肝肾来补气。

《左传》
现代医学的风湿病,只是借用“风湿”的名字,本质还是来自国外的rheumatism*。
早在公元前3世纪的古希腊一本《希波克拉底全集》中就已经出现了rheuma一词。
*注:风湿病一词的英文是rheumatism,其中对应“风湿”的词根rheuma。

希波克拉底,医学封面
William Heberden在18世纪开创了风湿病学,风湿病自此踏上现代医学的帆船。
而我国则是在1979年,才开办了首个风湿病专科。
翻译学家将“自身免疫病”这个概念引入国内时,为了老百姓方便理解,取了“风寒湿邪”之中风湿二字,同样称作了风湿病。
风湿病的歧义便是由此而来。

风湿病学之父William Heberden
如今我们谈起风湿病,大多是指代 风湿性关节炎 与 类风湿性关节炎 。
风湿性关节炎也被称作“风湿热”,主要是因为感染化脓性链球菌。
化脓性链球菌的构成成分,与人体某些组织的细胞构成相似。
免疫系统在清理这些侵入体内的细菌,会无意间伤及其他的正常组织,造成组织的发炎。

化脓性链球菌
因为这些组织在体内分布广泛,会引起多个地方的症状,严重的甚至会导致心脏炎症。
有句话这么形容风湿热的可怕:划过关节,咬住心脏。
不过随着阿司匹林、青霉素治疗的推广普及,如今这类疾病已经算不得危险。

阿司匹林
类风湿性关节炎也被称作“类风湿”,普遍认为也是体内免疫系统误伤了正常组织引起的。
危及关节时,关节会被破坏,使关节慢慢畸形,譬如双手呈鸡爪状,一看便知功能尽失。
更加严重的时候,甚至还会瘫痪、骨骼破坏、肌肉萎缩,若是不及时治疗,所有内脏器官都逃不过灾厄。

类风湿导致手掌变形、关节钙化
在WHO的分类中,风湿病按发病区域分为10大类,除了风湿热与类风湿外,风湿病还涵盖有不少于100种疾病。
其中耳熟能详的疾病并不少,痛风、系统性红斑狼疮、硬皮病、坏血病、骨质疏松都是不陌生的词汇。
现阶段大部分风湿病都还不能根治,只能控制病情维持生活质量,因此也被人戏称为“不死的癌症”。

或许是被病魔的威名所震慑,许多患者对治愈几乎不抱希望。
在不了解传统医学与现代医学之间的风湿差异时,不免会有很多可笑的事情来。
在病了之后,他们常常就四处寻找名为“祖传秘方”的神药。
且不说神药可能只是神棍祖传的骗钱秘方,弄错概念投错医也都是一场闹剧。
如果真不幸染上风湿病,最好的方法还是听医生的话,积极治疗才是正道。
现代医学其实已经为治疗风湿病,提供了许多有效的药物。

风湿病研究虽然已经是个老命题,但许多问题都“尚未完全明确”。
病因就是其中不明确的一种,链球菌是已经确定的引发风湿病的刺激原,因此细菌被认为有可能是“主谋”。
也有动物实验证明了支原体对动物有着相似的功效,但还未发现对人有相同效果。
支原体
找不到细菌作案的直接证据,科学家又瞄准了病毒,却始终无法重现关节炎的病症。
他们还注意到了某些家族较之随机人群,发病率较高,因此认为遗传可能在发病中起重要作用,但也只局限在“可能”。

关节疼痛与关节炎症
自从看到了调研数据表明风湿病男女发病率之比为1:(2~4),性激素也成为他们怀疑的因素。
他们建立的动物模型中,雌鼠对关节炎的敏感度确实较高,雄性发病率也相对低。
若是将雄鼠阉割、注射雌性激素后,关节炎的发病率则与雌鼠一样,可见性激素有起着一定作用。

但这些都不能证明哪一个才是爆发的主因。
甚至可能是多条件引起的风湿病,再在疲劳、潮湿、烟酒、营养问题的胁迫下爆发出来。
所以听老一辈的话,穿上秋裤必然能够感受温暖,却不一定能阻隔风湿疼痛。

再怎样,温度也比风度重要
虽然致病原因还不明确,但只要清晰发病机制,同样可以拟定医疗对策。
让我们看看现在较为认同的发病机制:一些人体内有部分细胞的标记出现了偏差,免疫系统容易识别错误。
当人体内的吞噬细胞识别到刺激因子入侵后,携带有这种标记的细胞会受到攻击。
即使刺激因素已经不存在了,免疫系统仍不断与不存在的“危险源”抗争。
这种情况会损伤自身的组织器官从而引起病变,逐渐发展成慢性炎症,这种情况与遗传有着一定的相关性。

了解了发病机制,也就清楚了治疗的方法,无非是控制炎症情况,或是让免疫系统不那么激动。
NSAIDs便是用作消炎镇痛的,也称为非甾类抗炎药。
这一类药物最早是阿司匹林时已经很有效,后来更多的水杨酸类药物被研发出来,用药针对性更强。

布洛芬,另一款非甾类抗炎药
DMARDs则是另一条道路,被称作慢作用抗风湿药物。
这些药物虽然无法直接消炎止痛,却通过不同的机制起到免疫抑制作用。
这类药物最有名的叫做甲氨蝶呤,美国风湿科医生就常常戏称自己为“甲氨蝶呤医生”。

20世纪50年代的甲氨蝶呤
还有一类药物同样有效果,叫做肾上腺皮质激素,其实主要就是指糖皮质激素。
这种药物起效较之其他药物更快,曾是第一线药物,只是长期使用可能诱发感染、骨质疏松、糖尿病、高血压等等疾病,停药过快还会产生病情反跳现象。
虽然糖皮质激素如此危险,但他起效快的特性依然适合重症患者使用。
当然,也有一些“祖传配方”中也会偷偷添加糖皮质激素,一旦证明配方见效快,卖出个好价格也就不是难事。

糖皮质激素
自风湿病发病至今早已过去2000多年,多少人的智慧投入其中,我们曾经连病因的方向都判断错误,直至如今也尚未完全确定其机理。
面对那些“现代病”,我们的认知会不会也存在谬误?
或许,只有会秃头的男士才能顶得住加班的压力,而不是加班让他们秃头。
*参考资料
类风湿关节炎, 医学百科.
金道龙,陈俊. 链球菌与风湿热[J]. 医学综述,2008,(04):611-612.
郭惠芳,高丽霞. 2014年风湿免疫病主要临床研究进展[J]. 临床荟萃, 2015,30(02):167-173.
郭惠芳,高丽霞. 2016年风湿免疫病学主要临床进展[J]. 临床荟萃, 2017,32(02):146-151.